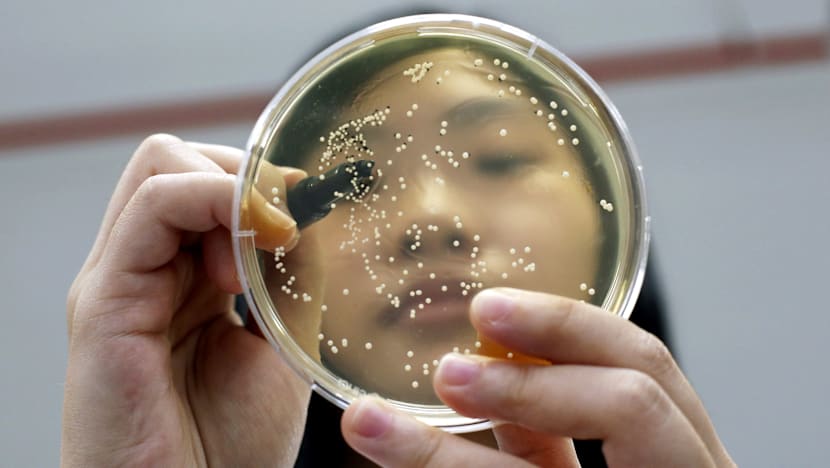
Researchers appeal for more patients to take part in clinical trials

Researchers appeal for more patients to take part in clinical trials
Many people are reluctant to participate in clinical trials, for fear of trial mishaps. However, researchers say there are safeguards in place to ensure that such studies, even the early-stage types, are safe. Photo: Reuters
SINGAPORE — Despite strides made in the past decade in biomedical research here, the public’s view of and willingness to take part in clinical trials have not caught up, say doctors and scientists.
“I don’t want to be a guinea pig” is the common refrain of potential participants, and recruiting sufficient volunteers remains a pressing challenge for many research studies.
“There is generally a lot of reluctance (to participate in clinical trials). Patients feel they are being guinea pigs by being part of a study rather than (that they are) getting the usual standard of care,” said Dr Ravindran Kanesvaran, president of the Singapore Society of Oncology, who is the principal investigator for several clinical trials in Singapore.
He estimated that only 3 per cent of cancer patients here may take part in clinical trials, a figure similar to that in the United States. Clinical trials are designed to study the effect of a new treatment or drug on humans.
The public perception that testing new drugs is risky was reinforced after a drug trial went awry in France last year. The Phase One trial of a pain medication — where the drug is tested on humans for the first time — left one man brain-dead and several other volunteers with permanent disabilities.
PARTICIPANTS’ RIGHTS ARE PROTECTED
But such trial mishaps are rare, and Dr Ravindran, also a consultant at the Division of Medical Oncology at the National Cancer Centre Singapore (NCCS), hopes for a “mindset change”.
For one, there are safeguards in place to ensure that trial studies, even the early-stage types, are safe.
All clinical trials in Singapore are regulated by the Health Sciences Authority (HSA) under the Health Products Act and Medicines Act.
According to a HSA spokesperson, there are currently 465 ongoing clinical drug trials in Singapore, all of which were reviewed and approved by an Institutional Review Board — an independent committee of medical professionals and non-medical members — before they commenced.
“The regulations on clinical drug trials are based on the principles of Good Clinical Practice (GCP), which is an internationally recognised standard for the conduct of clinical trials. Compliance with GCP provides assurance that the participants’ rights, safety and well-being are protected,” said the HSA spokesperson.
Dr Ravindran, who spoke to TODAY on the sidelines of the European Society of Medical Oncology Asia Congress last month, said drug trials adhere to strict protocols, and participants are monitored closely.
“Because of the close monitoring, we pick up side effects very early and we can treat them quickly. Trial participants usually undergo more frequent follow-ups and they are also in constant contact with the coordinator 24/7,” he added.
Besides drug trials, it is just as challenging to recruit participants for observational studies, which can be conducted without notifying or seeking approval from the HSA.
While clinical trials are designed to study the effects of a potential new treatment or drug on humans, participants of observational studies are observed for a period of time without new interventions, such as drugs, affecting the outcome. Researchers study the development of a disease in a given population, as well as the relationship between multiple risk factors and disease outcomes, said Dr Toh Sue-Anne, senior consultant at the National University Hospital’s (NUH) Division of Endocrinology.
One observational study is “Assessing the Progression to Type-2 Diabetes” (APT-2D), led by NUH. The study, which started early last year, is 1,900 participants short of its target of 2,300. It is “critical” to achieve the target number of participants by the end of this year for a meaningful analysis, said Dr Toh, its principal investigator.
SOME INCONVENIENCE, BUT ‘TWO-FOLD’ BENEFITS
The reasons for the poor participation rate include a lack of awareness about health research, inconvenience, and lack of direct benefits for the participant, said Dr Toh.
According to Dr Ravindran, whether a patient decides to join a trial study is likely to depend on his age and education level.
“Some of the older patients feel that they have lived a good life. They have the perception that the treatment is going to cause detriment to their quality of life and that it is best to let nature take its course,” he said.
The other group is less aware of the benefits and may feel it is complicated to participate. There needs to be more public education, such as forums, on how trial studies work, said Dr Ravindran. Designated clinics where potential study participants can get support and information may also help overcome barriers, he added. Ironically, the rigorous follow-ups, which help detect any early side effects from new drugs, may be one reason why patients decline or withdraw from a study.
“For example, a cancer patient on standard treatment may only need to come in once every three to four weeks for chemotherapy. But for some targeted therapy trials, they may have to come in (to the hospital) every week. Some may also need to be admitted to the hospital to be monitored closely,” said Dr Ravindran.
Participants in the APT-2D study make nine visits to the hospital within 3.5 years, and are reimbursed S$50 for every two-hour oral glucose tolerance test visit and S$200 for every three-hour euglycaemic-hyperinsulinemic clamp (EHC) test, which assesses their bodies’ ability to secrete insulin and respond to insulin.
Having access to trial therapies may offer hope to patients who are not doing well on existing standard treatments. For example, newer drugs have helped prolong the survival of lung cancer patients.
“Before targeted therapy came in, the standard of care for lung cancer was chemotherapy. That extended their survival by three months, which was not great at all, considering the toxicities were high and patients suffered a lot of side effects. With targeted therapy, certain groups of patients, particularly Asian female non-smokers with a gene mutation known as EGFR, can live up to 30 months, which is substantially longer than if they were on chemo,” said Dr Ravindran.
Participants receive the standard of care for free, even when there is no guarantee of getting the new trial drug in randomised studies. In a randomised controlled trial, one group is given the trial treatment while the control group is given an existing or standard treatment. In cases where there are no existing standard treatments, the control group may be given a placebo.
Mr Eng Tiang Sing, 62, who is currently a participant in the APT-2D study, said enrolling in the study means he gets to have his blood glucose level monitored more closely, at once every six months for a total of three-and-a half years. Found to be pre-diabetic about two years ago at an annual health check-up, Mr Eng said he has gained a better understanding of his risk of the disease.
“It’s a win-win situation; being on the study benefits the participant and also improves society on the whole,” said the retired civil servant.
Large-scale observational studies such as the APT-2D study enable doctors to address the root cause of the disease and not just treat its symptoms, said Dr Toh. Singapore is currently facing a diabetes epidemic, with the second-highest proportion of diabetics among developed nations, according to the International Diabetes Federation.
Dr Ravindran said better therapies would not be discovered if patients only stuck to standard treatments.
“For instance, our (existing) standard of care for many tumour types is not curing patients. People are struggling with side effects, just for a small benefit in survival. That’s why it’s important to push those boundaries,” he said.
THE INS AND OUTS OF CLINICAL TRIALS
PRIOR TO RECRUITMENT
Clinical trial investigators are required to fully and accurately inform prospective trial participants about all pertinent aspects of the clinical trial through a written informed consent document.
This includes the potential risks and benefits so that they can make informed decisions about the level of risk they are willing to accept. The study team will check the participants’ health and screen them based on the eligibility criteria outlined in the research protocol before they are enrolled in the trial.
DURING THE STUDY
The study team will schedule several clinic visits to conduct tests and check on the participants’ well-being. In addition, investigators are required to inform trial participants in a timely manner, if new information about the drug becomes available that may potentially affect the participants’ willingness to continue in the clinical trial. Participants may choose to withdraw from a clinical trial at any time without any penalty, even if the clinical trial has not been completed.
Information on local clinical drug trials is publicly available at www.hsa.gov.sg.
Source: Health Sciences Authority












